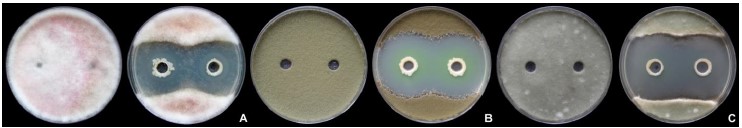

Действующие вещества
Оглавление
- Культуральные и физиолого-биохимические свойства
- Действие на вредные организмы
- Действие на растения
- Применение
- Токсикологические свойства и характеристики
- История
Культуральные и физиолого-биохимические свойства
Бактерия Pseudomonas asplenii, штамм 11 RW (ВКПМ В-13395) относится к типу Грациликуты (Gracilicutes), класс Скотобактерии (Scotobacteria), порядок не определён, семейство Псевдомонадовые (Pseudomonadaceae), род (Pseudomonas)[2].
Бактерии Pseudomonas aspleniiштамм 11 RW – короткие одиночные грамотрицательные палочки. Данный штамм – мезофил. Диапазон температур от 20ºС до 37ºС. Оптимум – 30±2ºС. Особенно хорошо развивается в нейтральных или слабощелочных условиях (диапазон pH – 5,5–8,0, оптимум – 7,0–7,5), способен расти при 4% NaCl в среде[3].
Культивирование на агаризованных средах R2A и ГМФ при 30°Cчерез сутки дает образование бежевых колоний, диаметром 1 мм. Через 72 часа – штамм выделяет флуоресцирующий пигмент, растворимый в воде[3].
Pseudomonas asplenii, штамм 11 RW (ВКПМ В-13395) обладает ярко выраженной протеолитической активностью (разжижает желатин), синтезирует липазу, утилизирует глюкозу, инозит и сорбит, оксидаз- и каталазположительный, способен продуцировать H2S, реакция Фогеса-Проскауэра отрицательная[3].
Pseudomonas asplenii,штамм 11 RW (ВКПМ В-13395) синтезирует фитогормон типа ауксинов и обладает фосфатмобилизующей активностью[3].

Фунгицидная активность штамма P. asplenii 11 RW
Фунгицидная активности штамма P. asplenii 11 RW против грибов Fusarium culmorum 63 (A), Cladosporium herbarum (B) и Alternaria alternate Д6 (C) в сравнении с контролем[4].
Действие на вредные организмы
Pseudomonas asplenii,штамм 11 RW (ВКПМ В-13395) обладает широким спектром фунгицидного действия, который был проверен на 108 штаммах фитопатогенных грибов различных родов, являющихся возбудителями заболеваний основных сельскохозяйственных культур, древесных и декоративных растений, в том числе: Alternaria, Fusarium, Cercospora, Phytophthora, Bipolaris, Pyricularia.
При высокой нагрузке фитопатогенного фона в лабораторных условиях данная бактерия показала способность ингибировать рост 106 из 108 проанализированных объектов. Устойчивость проявляли штаммы Fusarium solani и Fusarium oxysporum 96801[3].
Pseudomonas asplenii,штамм 11 RW (ВКПМ В-13395) проявляет бактерицидную активность. Методом диффузии в двухслойный агар было обнаружено подавление роста следующих штаммов бактерий: Pseudomonascarotovorum480,PseudomonassyringaeБИМ B-280, XanthomonasarboricolaB-614, XanthomonasarboricolaB-628, XanthomonasvasicolaB-618[3].
Установлено, что данный штамм синтезирует летучие соединения, обладающие фунгицидными действием против фитопатогенных грибов. Так в бесконтактных системах разрастание мицелия грибов Alternariatenuis,Drechslera avenae, Rhizoctonia solani и родаSeptoria под влиянием летучих метаболитов штамма полностью отсутствовало. Рост мицелия Fusariumoxysporum F-55071 и Fusarium sporotrichioides 58871не блокировался, но сильно ограничивался[3].
Летучие соединения, выделяемые данным штаммом, подавляют развитие структур бесполого размножения фитопатогенных грибов – конидий Alternaria tenuissima 481-101 иBipolaris sorokiniana. Кроме того, у B. sorokiniana у прорастающих конидий появляются аномалии развития, выражающиеся в изменении морфологии ростковых трубок, остановке в росте гиф с их последующим лизисом[3].
Действие на растения
Pseudomonas asplenii, штамм 11 RW (ВКПМ В-13395) обладает ростостимулирующим действием на широкий спектр растений. Обработка семян пшеницы, ячменя, кукурузы бактериальными суспензиями титром жизнеспособных клеток 109 КОЕ/мл, расходом суспензий 1 л/т и рабочего раствора 10 л/т оказывает положительное влияние на всхожесть, рост и развитие растений[3].
Ростостимулирующее действие на растения оказывают и газообразные метаболиты данного штамма[3].
Применение
Фунгицидные, бактерицидные, ростостимулирующие свойства бактерии Pseudomonas asplenii, штамм 11 RW (ВКПМ В-13395) позволили разработать и внедрить в сельскохозяйственное производство, в сфере защиты растений препарат Биокомпозит-Про, Ж с титром живых бактерий не менее 109 КОЕ/мл(АО «ЩелковоАгрохим»)[1].
Препарат прошел испытания и показал значительную эффективность при борьбе:
- с паршой, монилиальной гнилью, плодовой гнилью, мучнистой росой – на яблоне;
- с милдью, оидиум, серой гнилью – на винограде;
- фузариозной корневой гнилью, бурой пятнистостью, мучнистой росой, фитофторозом – на томате защищенного грунта[1].
Токсикологические свойства и характеристики
Pseudomonas asplenii, штамм 11 RW (ВКПМ В-13395) при использовании согласно регламенту применения не представляет опасности для окружающей среды, человека и животных[1].
В тестах на белых крысах и белых мышах установлено, что данный штамм не обладает вирулентностью, диссеминацией, токсичностью и токсигенностью и является безопасным для применения в сфере защиты растений[3].
Класс опасности
- 3 – для человека;
- 3 – для пчел[1].
История
Поиск нового штамма–антагониста Pseudomonas asplenii, штамм 11 RW (ВКПМ В-13395) проводился на базе Институт биохимии и физиологии микроорганизмов им. Г.К. Скрябина Российской академии наук и сектора биотехнологии отдела биологических исследований Акционерного общества «Щелково Агрохим». Авторство патента закреплено за Масленниковой Светланой Николаевной. Владелец патента: Акционерное общество "Щелково Агрохим". Начало действия – 2019.07.02[5].
2. Лысак В.В. Микробиология : учеб. пособие / В. В. Лысак. – Минск: БГУ, 2007 – 430 с
3. Масленникова С.Н. Ростстимулирующая и биоконтрольная активности штамма Pseudomonas asplenii 11RW. Современные проблемы медицины и естественных наук: сборник статей Международной научной конференции. Вып. 8, Йошкар-Ола, 15-19 апреля 2019 г. Мар. гос. ун-т. – Йошкар-Ола, 2019. – стр. 143 – стр. 145
4. Масленникова, С.Н. Антифунгальная активность ризосферной бактерии Pseudomonas asplenii 11RW против фитопатогенных грибов / С.Н. Масленникова, С.Д. Каракотов // IV Всероссийский съезд по защите растений с международным участием «Фитосанитарные технологии в обеспечении независимости и конкурентоспособности АПК России». Сборник тезисов докладов. – СПб.: ФГБНУ ВИЗР. – 2019. – С. 118.
5. RU 2 711 873 C1 Патент «Бактериальный штамм Pseudomonas asplenii 11RW для защиты растений от болезней». Владелец патента: Акционерное общество "Щелково Агрохим" (RU) Автор: Масленникова Светлана Николаевна (RU) Начало действия: 2019.07.02 Публикация: 2020.01.23 Подача: 2019.07.02
Пестициды, содержащие Pseudomonas asplenii штамм 11 RW (ВКПМ В-13395)
фунгициды, ДВ: Pseudomonas asplenii, штамм 11 RW (ВКПМ В-13395) (титр не менее 109 КОЕ/мл)
Рег. номер: 018-02-3837-1 до 24.10.2032 г. 3/3
(c) Справочник AgroXXI